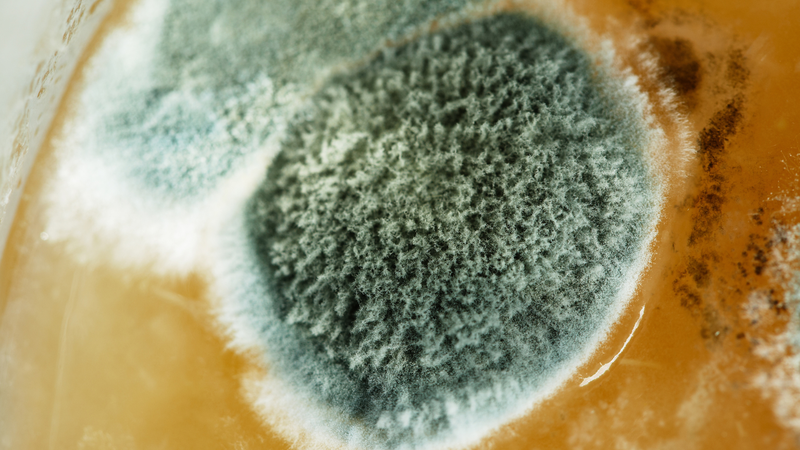
Bảo quản đông trùng hạ thảo không đúng cách sẽ gây nấm mốc

Từng làm ở Viện ISDS, nhiều năm cộng tác với CDC Thái Nguyên triển khai dự án phòng chống HIV/AIDS, 2 năm cộng tác với WHO.
Khánh Vy
11/09/2025
Mặc định
Lớn hơn
Đông trùng hạ thảo là một trong những dược liệu quý hiếm, được nhiều người lựa chọn để bồi bổ sức khỏe. Tuy nhiên, giá trị dinh dưỡng của loại dược liệu này chỉ được giữ nguyên nếu bảo quản đúng cách. Nếu bảo quản sai, đông trùng hạ thảo dễ bị mốc, hỏng, mất dưỡng chất, thậm chí gây hại cho sức khỏe. Vậy cách bảo quản đông trùng hạ thảo đúng là như thế nào?
Thực tế cho thấy, nhiều người tiêu dùng bỏ ra số tiền lớn để mua đông trùng hạ thảo nhưng lại chưa có kiến thức đúng về bảo quản. Kết quả là sản phẩm nhanh chóng bị mốc, biến đổi chất lượng hoặc mất mùi vị đặc trưng. Điều này không chỉ gây lãng phí kinh tế mà còn tiềm ẩn nguy cơ ngộ độc. Bài viết này sẽ cung cấp thông tin đầy đủ và dễ hiểu về cách để bảo quản đông trùng hạ thảo chuẩn khoa học, các dấu hiệu nhận biết khi sản phẩm bị hư hỏng và cách xử lý an toàn.
Để giữ được tối đa dưỡng chất, mỗi dạng đông trùng hạ thảo cần có cách bảo quản riêng. Việc áp dụng sai phương pháp có thể khiến sản phẩm nhanh chóng hỏng, mất giá trị dược liệu.
Đông trùng hạ thảo tươi chứa nhiều nước, vì thế dễ nhiễm vi khuẩn và nấm mốc.
Đây là dạng được sử dụng phổ biến vì thời gian bảo quản lâu và ít bị hỏng.
Sai lầm thường gặp: Nhiều người bảo quản đông trùng hạ thảo khô trong túi nilon thông thường, đặt cạnh bếp hoặc nơi ẩm thấp. Điều này khiến sản phẩm nhanh chóng bị mốc, mất giá trị dinh dưỡng.

Ngoài dạng tươi và khô, đông trùng hạ thảo còn được chế biến thành viên nang, bột hoặc nước uống. Mỗi loại có đặc thù riêng:
Lời khuyên: Khi mua sản phẩm chế phẩm, người tiêu dùng nên kiểm tra hạn sử dụng và hướng dẫn bảo quản trên nhãn để tránh sai sót.
Không phải ai cũng dễ dàng nhận ra đông trùng hạ thảo đã bị mốc hoặc kém chất lượng. Việc nắm rõ các dấu hiệu sau đây sẽ giúp người tiêu dùng tránh rủi ro cho sức khỏe.
Nhận biết bằng mắt thường:
Nhận biết bằng mùi:
Nhận biết qua kết cấu:

Đây là vấn đề được nhiều người quan tâm. Không ít người nghĩ rằng chỉ cần cạo bỏ lớp mốc là có thể tiếp tục dùng. Tuy nhiên, quan niệm này hoàn toàn sai lầm.
Vi nấm sinh ra trong sản phẩm mốc thường tiết aflatoxin - độc tố cực mạnh, được Tổ chức Y tế Thế giới (WHO) xếp vào nhóm tác nhân gây ung thư gan.
Độc tố này không bị phá hủy khi rửa, đun sôi hay phơi nắng.
Sử dụng lâu dài có thể gây ảnh hưởng nghiêm trọng đến gan, thận, hệ miễn dịch, đặc biệt nguy hiểm cho người già và trẻ em.
Khi phát hiện đông trùng hạ thảo đã bị mốc, thì đây là cách xử lý an toàn:

Đông trùng hạ thảo có giá trị cao cả về dinh dưỡng và kinh tế, nhưng việc bảo quản sai sẽ gây ra nhiều hậu quả:
Đông trùng hạ thảo là dược liệu quý hiếm, nhưng giá trị của nó chỉ được đảm bảo khi được bảo quản đúng cách. Người sử dụng cần chú ý:
Hiểu và thực hành đúng cách bảo quản đông trùng hạ thảo không chỉ giúp giữ nguyên dưỡng chất mà còn đảm bảo an toàn, nâng cao hiệu quả sử dụng và tránh lãng phí. Đây chính là cách để phát huy tối đa giá trị của loại dược liệu này.
Dược sĩ Đại học Nguyễn Tuấn Trịnh
Từng làm ở Viện ISDS, nhiều năm cộng tác với CDC Thái Nguyên triển khai dự án phòng chống HIV/AIDS, 2 năm cộng tác với WHO.